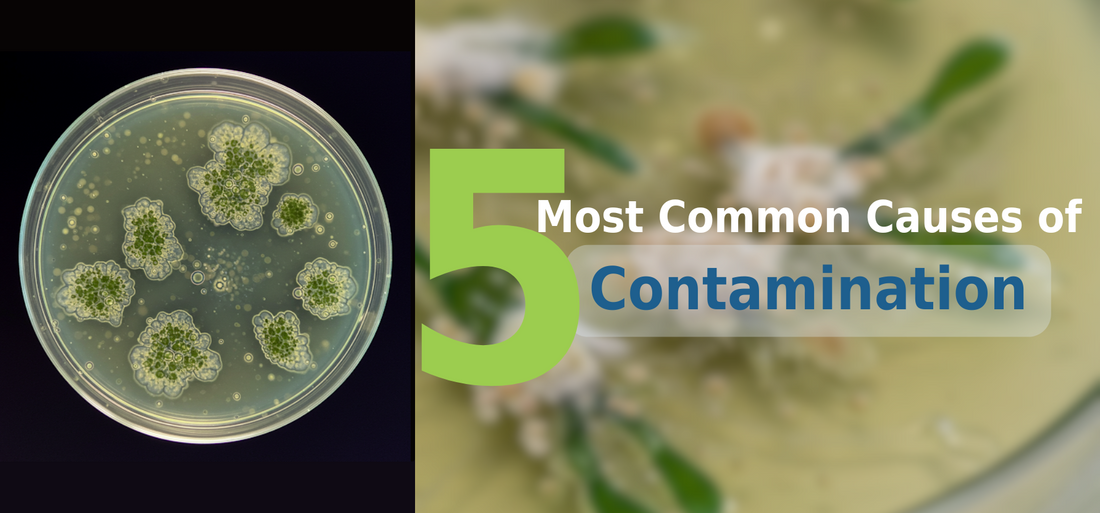

The 5 Most Common Causes of Contamination in Tissue Culture Labs
As a content and community manager, I leverage my expertise in plant biotechnology, passion for tissue culture, and writing skills to create compelling articles, simplifying intricate scientific concepts, and address your inquiries. As a dedicated science communicator, I strive to spark curiosity and foster a love for science in my audience.


Introduction
Scaling up your tissue culture production is impossible if you’re constantly battling contamination.
Contamination is one of the biggest challenges in tissue culture labs, often leading to failed cultures, wasted resources, and significant delays.
Whether it's bacterial, fungal, or viral, contamination can spread rapidly and compromise entire batches of plantlets. That’s why maintaining a strictly aseptic environment is non-negotiable when working with delicate plant tissues.
If you step into a well-established tissue culture facility, you’ll notice one thing immediately: lab personnel are never seen without their protective gear. They wear dedicated lab clothing, separate from their everyday attire, masks, head covers, and gloves to minimize the risk of bringing in unwanted contaminants.
Every detail, from sterilization protocols to airflow management, is meticulously controlled to prevent contamination from sneaking in.
But despite these precautions, contamination still finds its way into tissue culture labs—sometimes through unnoticed gaps in protocol, improper handling, or even through the very materials used in the process. Understanding the most common sources of contamination is the first step toward eliminating them.
In this blog, we’ll explore the five most common causes of contamination in tissue culture labs, how they occur, and what you can do to prevent them. Whether you're running a small lab or a large-scale operation, identifying and addressing these issues will help you improve culture success rates and streamline your production.
Let’s dive in.
Save your cultures from contamination using just 1-2 ml PPM/liter of tissue culture media.
1. The Human Factor: Unintentional Introduction by Personnel
Despite the best intentions and rigorous training, personnel remain one of the most frequent sources of contamination in tissue culture labs. We, as humans, are walking ecosystems, carrying a vast array of microorganisms on our skin, hair, and even in our breath. Every entry into the sterile environment presents a potential breach in aseptic conditions.
-
Inadequate Personal Protective Equipment (PPE): Failing to wear or properly utilize sterile lab coats, gloves, face masks, and hairnets is a direct pathway for contaminants to enter the cleanroom and culture areas. Skin cells, hair, and respiratory droplets can easily harbor bacteria and fungi.
-
Improper Gloving Techniques: Even when gloves are worn, incorrect donning or doffing procedures can transfer contaminants. Touching non-sterile surfaces before handling cultures or removing gloves improperly can negate their protective function.
-
Talking, Coughing, and Sneezing: Expelling respiratory droplets directly over or near open cultures is a significant contamination risk. While masks offer a barrier, even brief moments of unprotected communication can introduce unwanted microorganisms.
-
Rushed Procedures and Lack of Attention to Detail: When time is a constraint or focus wavers, personnel may inadvertently compromise aseptic techniques, such as leaving culture vessels open for too long or using non-sterile materials.
-
Bringing Non-Sterile Items into the Cleanroom: Pens, notebooks, personal electronic devices, or even clothing items that haven't been properly sterilized can introduce a diverse range of contaminants into the controlled environment.
2. Airborne Contaminants: The Invisible Threat
The air within a tissue culture lab, despite filtration systems, can still harbor a variety of microbial contaminants, including fungal spores and bacterial cells attached to dust particles.
-
Inadequate Air Filtration Systems: High-Efficiency Particulate Air (HEPA) filters are crucial for removing airborne contaminants. However, if filters are not regularly maintained, tested for integrity, or are of insufficient quality for the lab's needs, they can become a source of contamination.
-
Air Currents and Movement: Excessive movement within the cleanroom, rapid opening and closing of doors, and even drafts from ventilation systems can stir up settled particles and increase the risk of airborne contamination settling onto cultures.
-
Contaminated Equipment Surfaces: If equipment within the cleanroom, such as laminar flow hoods or incubators, is not regularly and effectively disinfected, settled airborne contaminants can be resuspended and pose a threat.
-
Introduction of Contaminated Materials: Bringing non-sterile media components, glassware, or other supplies into the cleanroom can introduce a new source of airborne contaminants as particles are shed from these items.
-
Poor Cleanroom Design and Maintenance: Inadequate sealing of walls, ceilings, and doors, as well as infrequent or improper cleaning protocols, can allow for the ingress and accumulation of airborne contaminants.
3. Contaminated Media and Reagents: The Hidden Source
The very substances intended to nourish your plant cultures can, unfortunately, become a source of contamination if not properly prepared, sterilized, or stored.
-
Non-Sterile Water: Water is a primary component of tissue culture media. Using non-sterile or poorly purified water introduces a wide range of potential contaminants, including bacteria, fungi, and even endotoxins.
-
Contaminated Stock Solutions: Stock solutions of hormones, nutrients, and other media components can become contaminated during preparation, storage, or repeated use if aseptic techniques are not strictly followed.
-
Improper Sterilization Procedures: Autoclaving is the most common method for sterilizing media and glassware. However, insufficient sterilization time, temperature, or pressure can lead to the survival of heat-resistant microbial spores.
-
Filter Sterilization Issues: For heat-sensitive components, filter sterilization using sterile membrane filters is necessary. However, filter integrity can be compromised, or the filtration process itself can introduce contamination if not performed correctly.
-
Contaminated Commercial Media: While less common, even commercially prepared media can occasionally be contaminated during manufacturing or packaging if quality control measures are not stringent enough.
4. Non-Sterile Equipment and Supplies: The Tangible Risk
Any equipment or supply that comes into direct or indirect contact with your cultures must be sterile to prevent the introduction of contaminants.
-
Insufficiently Sterilized Glassware and Plasticware: Reusing glassware and plasticware without proper cleaning and sterilization (e.g., autoclaving or dry heat sterilization) is a major source of contamination in tissue culture. Even disposable plasticware can be contaminated if packaging is compromised or handling is careless.
-
Contaminated Instruments: Surgical instruments, scalpels, forceps, and other tools used for explant preparation and subculturing must be meticulously sterilized before each use, typically through autoclaving or chemical sterilization.
-
Laminar Flow Hood Contamination: While designed to provide a sterile working environment, laminar flow hoods themselves can become contaminated if not regularly cleaned and disinfected. Improper use, such as storing excessive materials within the hood or disrupting the airflow, can also compromise sterility.
-
Contaminated Water Baths and Heat Blocks: Water baths used for thawing cryopreserved cultures or heat blocks used for media preparation can become breeding grounds for microorganisms if the water is not regularly changed and disinfected.
-
Compromised Packaging of Sterile Supplies: Tears, punctures, or improper sealing of packaging for sterile petri dishes, pipettes, and other disposables can allow contaminants to enter.
5. Cross-Contamination: The Silent Spread
Once a contamination event occurs, it can easily spread to other cultures and areas of the lab if proper containment and cleaning protocols are not in place.
-
Working with Multiple Cultures Simultaneously: Opening multiple culture vessels at the same time significantly increases the risk of airborne contaminants or contaminants from one culture inadvertently entering another.
-
Reusing Pipettes or Instruments Without Sterilization: Using the same pipette or instrument for different cultures without proper sterilization between uses is a direct pathway for transferring contaminants.
-
Spills and Splatters: Media spills or splatters can create a moist environment where microorganisms can thrive and spread to surrounding surfaces and equipment.
-
Inadequate Cleaning and Disinfection Protocols: Failure to regularly and effectively clean and disinfect work surfaces, equipment, and incubators allows contaminants to persist and spread.
-
Lack of Segregation of Contaminated Cultures: Keeping contaminated cultures in the same area as healthy cultures increases the risk of further spread, especially if vessels are not properly sealed.
Understanding these five common causes of contamination is the first crucial step in establishing and maintaining a successful and productive tissue culture lab. By implementing rigorous aseptic techniques, paying meticulous attention to detail, and consistently monitoring your processes, you can significantly minimize the risk of these unwanted invaders and ensure the healthy growth and scalability of your valuable plant cultures.

Plant Cell Technology Helps Tissue Culture Enthusiasts Perform Tissue Culture the Right Way!
At Plant Cell Technology, we are passionate about empowering tissue culture enthusiasts to refine their skills and achieve remarkable results. Our Master Class is designed for individuals at all levels, from beginners to seasoned professionals, offering in-depth guidance on mastering the art of tissue culture.
The Master Class delves into critical areas, including best practices, troubleshooting techniques, and innovative approaches, such as meristem culture and synthetic seed production, to help you advance in tissue culture.
With expert-led sessions, hands-on demonstrations, and a collaborative learning environment, participants gain the confidence and expertise they need to excel.
Students who attend the Master Class often share glowing feedback about their experience:
"The step-by-step guidance and practical tips were exactly what I needed to improve my techniques."
"I loved the interactive sessions! They made complex topics so easy to understand."
"This class transformed the way I approach tissue culture. I feel more confident and prepared than ever."
Ready to elevate your tissue culture skills?
Join our Master Class today and discover how Plant Cell Technology can help you perform tissue culture the right way!
Blog Categories
View by Level
Popular Blogs

How Tissue Culture Supports Vertical Farming and Urban Agriculture?
Introduction If you've ever seen a large-scale vertical farm, with its towering racks of perfect, vibrant greens, you might wonder...
Read More
How Bioreactors Are Revolutionizing Large-Scale Micropropagation?
Introduction Have you ever wondered what the secret is to producing thousands, or even hundreds of thousands, of identical, healthy...
Read MoreSubscribe to Our Newsletter
Join the conversation
Your email address will not be published. Required fields are marked